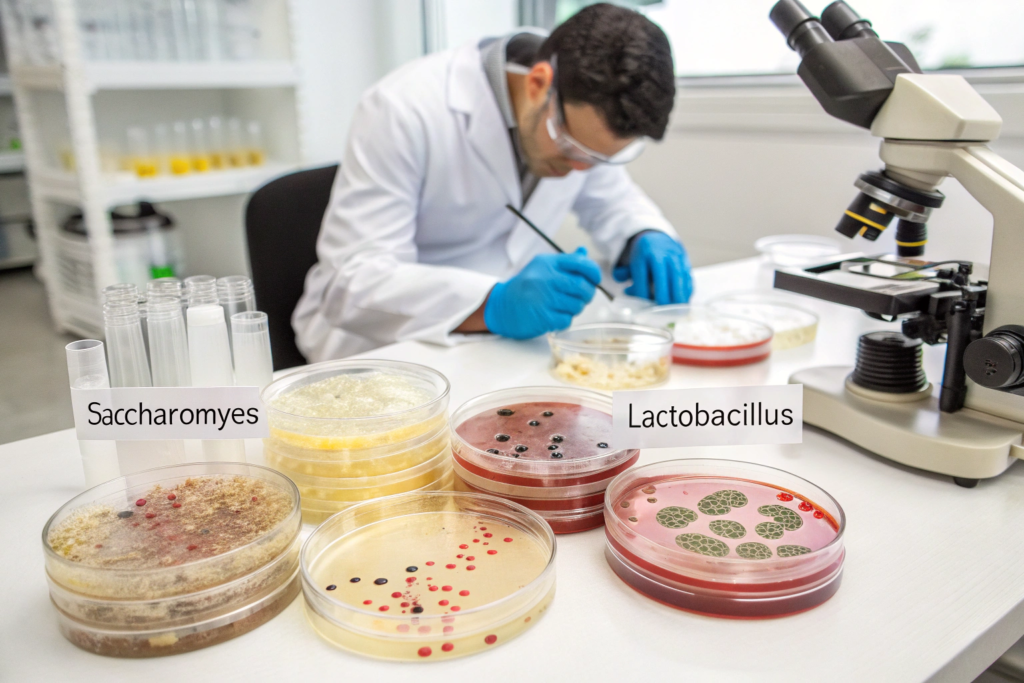

You taste a coffee described as "anaerobic thermal shock maceration" with notes of strawberry jam, rum, and dried mango. This isn't science fiction—it's the cutting edge of coffee processing, where traditional methods are being radically reimagined. The space between harvest and drying has become coffee's most exciting innovation frontier, transforming how flavors develop and what's possible in the cup.
The latest innovations in coffee processing focus on controlled fermentation, hybrid methods, thermal manipulation, and scientific precision. Key developments include anaerobic fermentation, carbonic maceration, thermal shock processing, enzymatic treatments, and ultrasound-assisted methods. These techniques allow producers to create unprecedented flavor profiles by manipulating temperature, oxygen, microbes, and time with laboratory-like precision.
So, how are these methods moving from experimental lots to commercial availability, and what do they actually do to the coffee? The innovation wave represents a fundamental shift from removing fruit as efficiently as possible to actively engineering flavor development through biochemical manipulation. Let's explore the most significant advances and their implications.
How Is Controlled Fermentation Revolutionizing Flavor?
Fermentation is no longer just a necessary step to remove mucilage—it's become a primary flavor development tool where variables are meticulously controlled to produce specific taste outcomes.
By manipulating oxygen levels, temperature, microbial populations, and time, processors can guide fermentation toward targeted flavor profiles rather than accepting whatever naturally occurs.
What Is Anaerobic Fermentation Really Doing?
Anaerobic (oxygen-free) fermentation involves:
- Sealed tanks that exclude oxygen completely
- Controlled temperatures typically lower than traditional fermentation
- Specific timeframes ranging from 24 hours to several days
- Potential additives like specific yeast strains or fruit matter
The oxygen-free environment favors lactic acid bacteria over acetic acid bacteria, producing creamy, yogurt-like flavors rather than vinegar-like sharpness. Extended anaerobic periods can develop intense fruit and wine characteristics that would be unstable in aerobic conditions.
How Does Carbonic Maceration Differ?
Borrowed from winemaking, carbonic maceration involves:
- Whole cherries fermented in CO2-filled sealed tanks
- Intracellular fermentation occurs inside intact fruit cells
- Unique ester development creating bright, sparkling fruit notes
- Typically shorter durations than submerged anaerobic
The method gained fame through Competition lots from producers like Diego Bermudez in Colombia, producing wildly fruity profiles that challenged traditional coffee flavor boundaries. This intracellular approach creates different chemical pathways than pulp-fermented methods.

What Role Does Temperature Manipulation Play?
Temperature control has moved from basic weather adaptation to active thermal engineering, dramatically affecting fermentation speed and microbial activity.
By precisely heating or cooling coffee at specific stages, processors can accelerate desirable reactions, halt unwanted ones, or create entirely new flavor pathways.
How Does Thermal Shock Processing Work?
Thermal shock methods involve:
- Rapid temperature changes at precise moments
- Hot water immersion followed by cold water immersion
- Cell structure alteration that affects extraction and fermentation
- Flavor compound preservation or development
For example, some innovators briefly immerse cherries in hot water (60-70°C) to break down cell walls, then immediately cool them to preserve delicate aromatics that would otherwise volatilize. This thermal engineering can intensify fruit notes while reducing undesirable vegetal characteristics.
What About Cryogenic or Cold Fermentation?
- Extended cold fermentation at 10-15°C for several days
- Slow microbial activity favoring different flavor development
- Preservation of delicate aromatics that heat would destroy
- Energy intensive but producing unique results
These temperature-extended processes create flavor profiles impossible at traditional ambient temperatures, though at higher cost and complexity. At BeanofCoffee, we've experimented with controlled thermal variations to develop specific flavor notes in our Yunnan lots.

How Are Enzymes and Microbes Being Engineered?
The most scientific frontier involves directly manipulating the biochemical actors in fermentation through added enzymes, selected yeast strains, or bacterial cultures.
This approach treats coffee processing more like craft brewing or cheesemaking, where specific microbes are cultivated and introduced to create predictable outcomes.
What Are Added Enzymes Doing?
Commercial enzymes can:
- Target specific mucilage components for more controlled breakdown
- Generate specific flavor precursors that develop during roasting
- Reduce processing time while maintaining quality
- Create consistency across varying raw materials
For example, pectinase enzymes break down pectin more efficiently than natural fermentation alone, potentially reducing water usage while creating cleaner cups. This enzymatic precision offers control that natural microbes cannot guarantee.
How Is Selective Inoculation Changing Processing?
Rather than relying on ambient microbes, some processors:
- Culture specific yeast strains (often from wine or beer)
- Introduce lactic acid bacteria for specific acidity profiles
- Control microbial succession through staged additions
- Create signature profiles through proprietary cultures
The microbiome management approach allows replicating successful fermentations year after year, addressing a major challenge in naturally fermented coffees.
What Hybrid Methods Are Emerging?
Many of the most exciting innovations combine elements from multiple traditional methods, creating entirely new categories beyond washed, natural, or honey.
These hybrids often aim to capture the best characteristics of different approaches while minimizing their respective drawbacks.
How Do "Honey-Plus" Methods Work?
Building on traditional honey processing:
- Partial washing followed by drying with varied mucilage levels
- Mucilage manipulation through brushing or scraping
- Intermediate fermentations between washing and drying
- Color spectrum expansion beyond white/yellow/red/black
Some processors create gradient honey lots where different mucilage percentages are tried on the same harvest to determine optimal balance for that specific coffee. This empirical optimization represents a more scientific approach than traditional honey categorization.
What About Washed-Natural Hybrids?
Methods that combine washed clarity with natural fruitiness:
- Brief aerobic fermentation before washing
- Reintroduction of fruit material after washing
- Staged drying with fruit contact at specific phases
- Double fermentation processes
These bridge methods attempt to capture natural processing's fruit intensity while maintaining washed processing's cleanliness and consistency.

What Equipment Innovations Enable These Methods?
Advanced processing requires specialized equipment that goes far beyond traditional fermentation tanks and drying beds.
From temperature-controlled reactors to ultrasound devices to analytical instruments, the toolkit for cutting-edge processing resembles a food science laboratory.
What Specialized Fermentation Equipment Exists?
- Temperature-controlled stainless tanks with monitoring sensors
- Pressure-adjustable vessels for carbonic maceration
- Paddle mixers for even fruit contact
- pH and Brix meters for real-time fermentation monitoring
- Gas analysis equipment to track CO2 and oxygen levels
This precision equipment allows replication of successful experiments at commercial scale, though at significant investment that limits accessibility to well-funded producers.
How Are Drying Innovations Supporting New Methods?
- Temperature- and humidity-controlled dryers replacing sun-drying
- Multi-stage drying protocols with different conditions per stage
- Vacuum drying for delicate lots
- Fluidized bed dryers for extremely even results
- Moisture monitoring throughout rather than just at completion
Controlled drying preserves the complex flavors developed during innovative fermentation, where traditional sun-drying might degrade them through temperature fluctuations or inconsistent drying rates.

What Are the Practical Implications for Buyers?
These innovations aren't just academic—they're creating new market categories, changing quality expectations, and raising questions about authenticity versus manipulation.
Buyers need to understand what different methods actually produce, their scalability, and whether they represent sustainable advancements or passing fads.
How Do These Methods Affect Flavor Consistency?
- Increased control can improve lot-to-lot consistency
- Higher risk if controlled conditions aren't perfectly maintained
- Greater differentiation between producers with vs. without advanced technology
- Potential for over-manipulation creating generic "processed" flavors
The best implementations enhance origin character rather than masking it with processing fingerprints. When we experiment at BeanofCoffee, we focus on highlighting our Yunnan terroir rather than transforming it into something unrecognizable.
What About Cost and Accessibility?
- Higher investment in equipment and expertise
- Smaller batch sizes for many experimental methods
- Premium pricing reflecting increased labor and risk
- Limited availability outside pioneering farms and regions
- Education requirement for buyers to understand what they're purchasing
These factors mean innovative processed coffees will likely remain premium niche products rather than replacing traditional methods for bulk production.

Conclusion
The latest coffee processing innovations represent a paradigm shift from passive fermentation management to active flavor engineering through controlled environments, temperature manipulation, microbial management, and hybrid methodologies. While traditional methods will continue to dominate volume production, these advances are expanding coffee's flavor possibilities and redefining quality potential.
The most promising innovations enhance rather than obscure origin character, are environmentally sustainable, and can be scaled to benefit broader producer communities. As these methods mature, they'll likely influence mainstream processing through trickle-down knowledge and technology adaptation. If you're interested in exploring how innovative processing can create unique flavor profiles for your brand, contact our export manager, Cathy Cai, at cathy@beanofcoffee.com. We're experimenting with these methods on our Yunnan farms and can share both the exciting results and practical realities.
